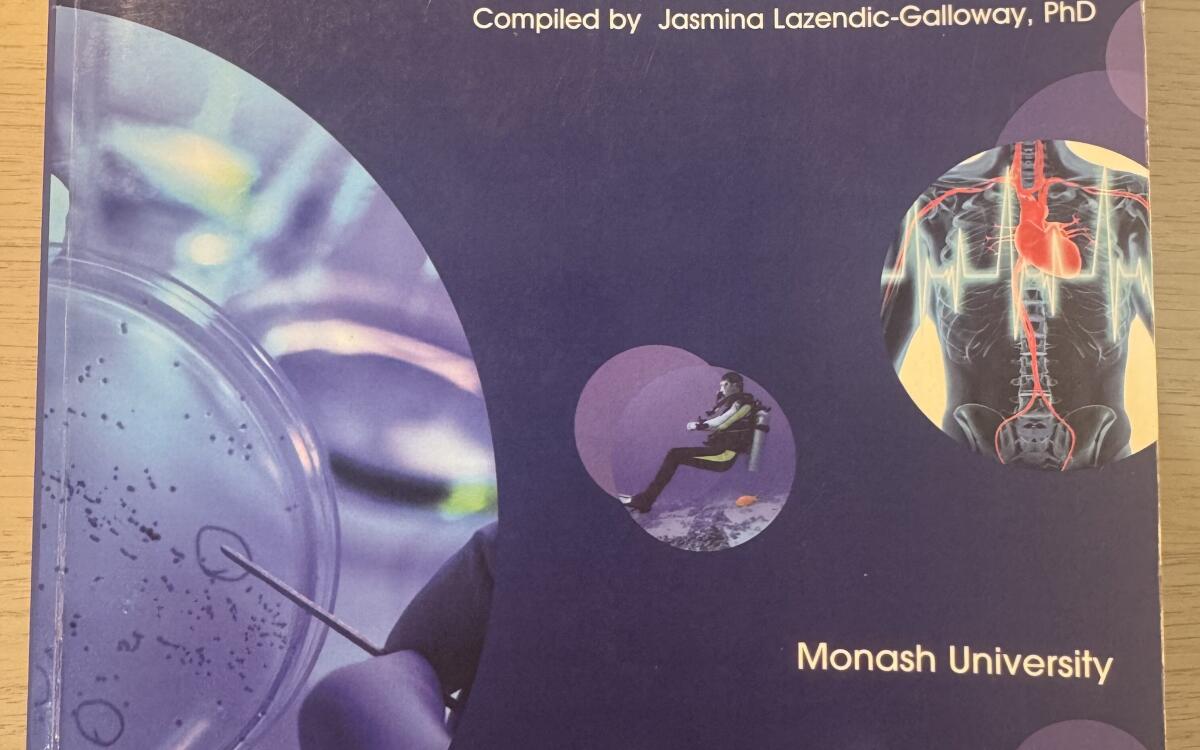

Physics for Biosciences CB
Giancoli
978-1-4860-0928-2
$40
Excellent
Melbourne-based. Meet up at Unimelb or postage at buyer's expense. (Yellow highlighting on the first page)
29th November, 2025
I'm good to meet on campus
I'm good to meet in the city
Contact Serhan to buy this textbook (before someone else does!)
You'll need to login to your StudentVIP account in order to contact Serhan.